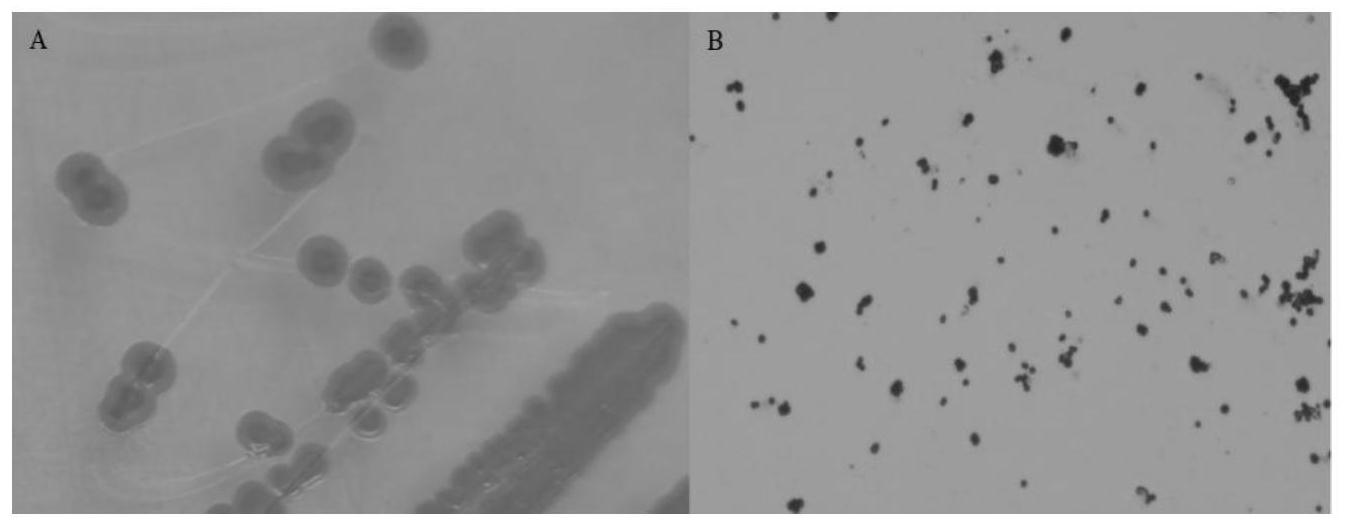

授权公布号:CN115029274B
产类胡萝卜素的奇异球菌属新菌株及其用途
有效
申请
2022-06-23
申请公布
2022-09-09
授权
2024-01-23
预估到期
2042-06-23
| 申请号 | CN202210718987.5 |
| 申请日 | 2022-06-23 |
| 申请公布号 | CN115029274A |
| 申请公布日 | 2022-09-09 |
| 授权公布号 | CN115029274B |
| 授权公告日 | 2024-01-23 |
| 分类号 | C12N1/20;C12P23/00;C12R1/01N |
| 分类 | 生物化学;啤酒;烈性酒;果汁酒;醋;微生物学;酶学;突变或遗传工程; |
| 申请人名称 | 宜宾五粮液股份有限公司 |
| 申请人地址 | 四川省宜宾市岷江西路150号 |
专利法律状态
2024-01-23
授权
状态信息
授权
2022-09-30
实质审查的生效
状态信息
实质审查的生效;IPC(主分类):C12N1/20;申请日:20220623
2022-09-09
公布
状态信息
公布
摘要
本发明属于微生物发酵技术领域,具体涉及产类胡萝卜素的奇异球菌属新菌株及其用途。目前,现有报道其他类异球菌产类胡萝卜素很少,还有待进一步开发产类胡萝卜素的新菌种。本发明提供了一种产类胡萝卜素的奇异球菌属新菌株,保藏编号为CGMCC NO.22044。本发明的奇异球菌属新菌株的温度耐受为20‑40℃,乙醇耐受浓度为≤6%,盐度耐受为≤4%,pH耐受范围为5‑10;能够高产类胡萝卜素,产量达到262.5ppm。本发明新菌株为产胡萝卜素提供新的功能微生物菌,丰富了微生物的资源,在医药、食品、化妆等领域具有很好的应用价值。